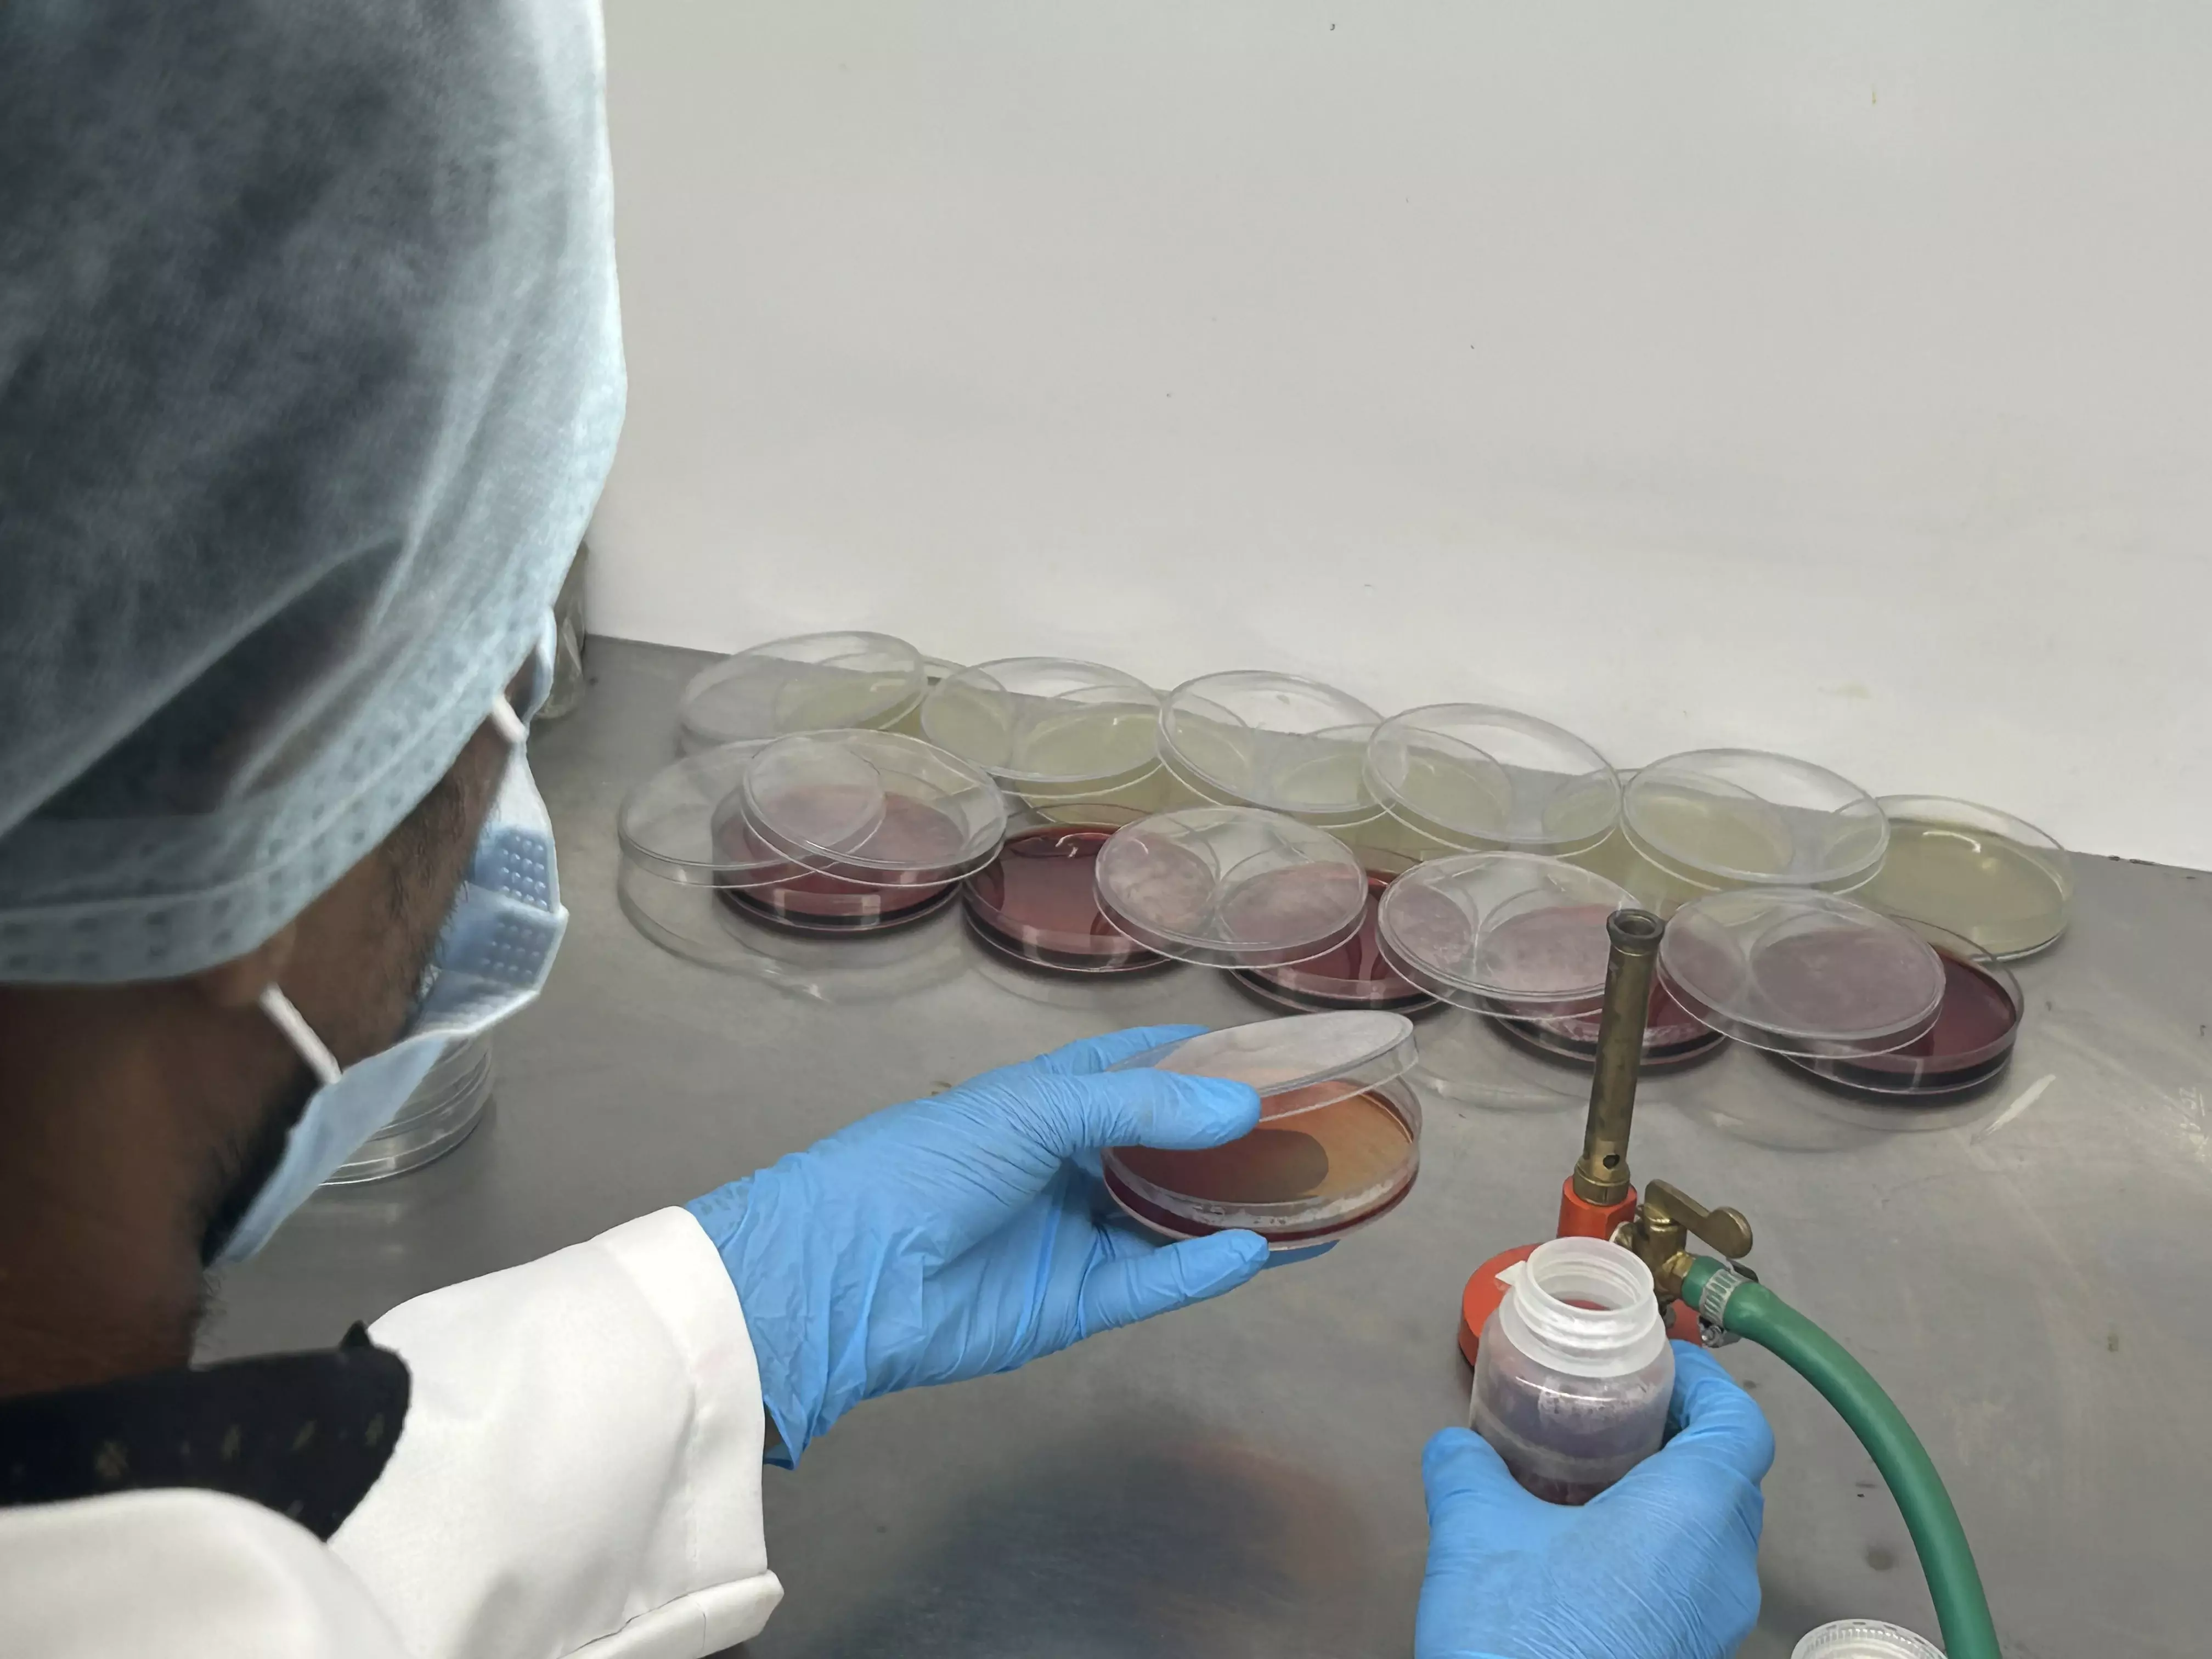
environmental testing laboratory in Mangalore

NABL Accredited Environmental Laboratory in Mangalore – Reliable Water, Air & Soil Testing Services

Environmental Laboratory in Mangalore - HECS
Environmental quality is a key factor in achieving sustainable growth, especially in fast-developing industrial cities like Mangalore. Maintaining clean water, breathable air, and uncontaminated soil is essential for public health, regulatory compliance, and corporate responsibility. To ensure these standards, businesses and institutions rely on NABL accredited environmental laboratories — trusted for their accuracy and scientific reliability.
HECS Environmental Laboratory in Mangalore stands among the top NABL accredited laboratories in India, offering end-to-end testing solutions for water, air, soil, wastewater, and pollution analysis. Recognized as one of the best environmental laboratories and testing companies in India, HECS delivers precise, certified results that meet national and international standards. Backed by advanced technology, skilled professionals, and decades of environmental expertise, HECS helps industries, EPC contractors, and institutions achieve full compliance with confidence.
Whether it’s verifying water quality, assessing soil composition, or monitoring air pollution, HECS remains the preferred choice for accurate, NABL-certified environmental testing in Mangalore and across India.
What is a NABL Accredited Environmental Laboratory?
A NABL Accredited Environmental Laboratory is a testing facility recognized by the National Accreditation Board for Testing and Calibration Laboratories (NABL) — India’s official accreditation body under the Quality Council of India. NABL accreditation confirms that a laboratory operates with technical competence and follows globally accepted testing standards (ISO/IEC 17025).
Why NABL Accreditation Matters:
Accuracy: Ensures data reliability for environmental audits and compliance.
Credibility: Accepted by government bodies, regulatory authorities, and clients.
Compliance: Helps industries meet environmental norms like CPCB and SPCB guidelines.
Mandatory third-party lab testing through NABL-accredited laboratories for all industrial compliance reports, ensuring accurate verification of environmental parameters as per EC and CTO conditions.
Choosing a NABL certified testing lab in Mangalore ensures you receive results that are both scientifically validated and legally recognised — a critical factor for project approvals, permits, and sustainability certifications.
1. Types of Environmental Testing Services Offered
HECS offers comprehensive environmental testing and analysis for water, air, soil, stack emissions, and industrial waste to ensure compliance with national and international standards.
2. Water Testing Laboratory in Mangalore
From potable water to industrial effluent, HECS provides advanced chemical and microbiological water analysis in Mangalore — ensuring safety for both consumption and discharge.
3. Air Quality Testing Laboratory in Mangalore
Air pollution monitoring is essential in urban and industrial areas. HECS’s air testing services analyse ambient air and indoor air quality for particulate matter, gases, and volatile compounds — enabling companies to meet environmental and safety norms.
4. Stack Emission Testing in Mangalore
HECS conducts Stack Testing and Flue Gas Analysis in Mangalore to measure emissions from boilers, furnaces, DG sets, and other industrial stacks. These tests help industries comply with CPCB and KSPCB emission standards, ensuring reduced air pollution and cleaner operations.
5. Wastewater & Pollution Testing Laboratory
HECS’s wastewater testing lab in Mangalore specializes in analyzing sewage, industrial effluent, and treated water to verify compliance with CPCB discharge standards. This supports sustainable water reuse and pollution reduction efforts.
6. Industrial Water Testing & Environmental Monitoring Services
Industries depend on HECS’s environmental monitoring services in Mangalore for ongoing audits, effluent testing, and environmental management. These services help maintain operational permits, improve compliance, and reduce environmental risks.
Why Choose a NABL Certified Testing Lab in Mangalore?
Working with a NABL accredited laboratory like HECS ensures precision, credibility, and compliance. Non-accredited labs may provide results, but those reports lack regulatory recognition — which can lead to project delays or penalties.
Feature |
| Non-Accredited Lab |
|---|---|---|
Accuracy | International Standards (ISO/IEC 17025) | Unverified Methods |
Recognition | Accepted by CPCB, SPCB, ISO bodies | Limited acceptance |
Data Integrity | Audited and Traceable | Unverified |
Compliance | Legal and Environmental Certification | Not Eligible |
HECS combines NABL recognition with deep technical expertise to deliver reliable, auditable data — trusted by regulators, clients, and consultants alike.
Industries We Serve
HECS Environmental Testing Laboratory in Mangalore supports a diverse range of industries and institutions:
Construction & Real Estate
Supporting builders, developers, and contractors with soil, water, and air quality testing to ensure compliance with environmental norms and project sustainability.
Manufacturing & Engineering
Serving industrial units across Mangalore’s Baikampady and Surathkal industrial belts — including petrochemical, metal fabrication, and machinery sectors — for emission, effluent, and waste quality testing.
Oil & Petrochemical Industries
Partnering with key players around Mangalore Refinery and Petrochemicals Limited (MRPL) and related industries to conduct mandatory environmental and wastewater compliance tests.
Ports & Logistics
Assisting Mangalore Port and related logistics operators in marine water quality testing, sediment analysis, and pollution monitoring to meet coastal regulations.
Educational & Research Institutions
Collaborating with universities and technical institutions in Mangalore for academic research, environmental analysis, and lab-based projects.
Hospitals & Healthcare Facilities
Testing biomedical waste, water quality, and ambient air to maintain hygiene and meet CPCB and KSPCB norms for medical institutions.
EPC Contractors & Infrastructure Projects
Providing analytical support for large-scale infrastructure works such as highways, bridges, and industrial estates in and around Mangalore.
Environmental Consultants & Auditors
Partnering with consultants for data-driven environmental audit reports and third-party verification of sampling results.
Each client benefits from certified environmental sample testing in Mangalore that supports both compliance and sustainability initiatives.
How HECS Ensures Accurate & Reliable Results?
At HECS, precision begins with technology and ends with trust. The laboratory uses Advanced instruments for chemical, microbiological, and physical testing — ensuring every sample is analyzed with scientific accuracy.
Key strengths include:
- Advanced Instruments: GC, AAS, UV Spectrophotometer, and microbiological analyzers.
- Qualified Experts: NABL-trained chemists, microbiologists, and environmental engineers.
- Fast Turnaround: Quick sample collection, testing, and certified reporting.
- End-to-End Compliance: Results aligned with CPCB, ISO, and MoEF standards.
Whether it’s industrial water testing, air quality assessment, or wastewater analysis, HECS ensures that every report you receive is defensible, traceable, and regulatory-compliant.
HECS – The Best Environmental Laboratory in India for Reliable Testing & Compliance
When it comes to ensuring accuracy, compliance, and environmental safety, HECS stands as the best environmental laboratory in India and a trusted partner for industries across sectors. With its NABL-accredited environmental laboratory in Mangalore, HECS combines scientific excellence with decades of environmental expertise to deliver results you can depend on.
Recognised as the best environmental company for comprehensive testing and consultancy, HECS provides reliable solutions for water testing, air quality analysis, soil testing, and pollution monitoring — all under one roof. Every report is verified, certified, and compliant with regulatory standards, helping businesses meet environmental obligations and achieve sustainability goals.
If you’re seeking accurate results, expert consultation, and end-to-end environmental compliance, choose HECS — the best NABL accredited environmental testing partner in India.
📞 Contact HECS today to schedule your environmental sample testing and get your NABL-certified report delivered with precision, speed, and trust.
💡 Request a sample test today and get your report certified by NABL experts at HECS Environmental Laboratory in Mangalore.
Share this post:





